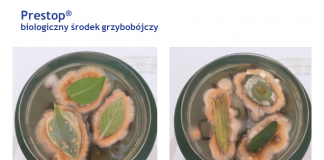
Nowe możliwości uprawy truskawek bez pozostałości

Tag: Perlka
Nowe możliwości uprawy truskawek bez pozostałości
Ważnym czynnikiem definiującym plonowanie truskawek i ich jakość jest właściwe dostosowanie nawożenia i ochrony. Mówił o tym w ramach on-line Akademii Uprawy Truskawek 2020...
Nawozy dla jagody kamczackiej z wartością dodaną
Okazuje się, że bardzo dobre efekty podczas zakładania plantacji jagody kamczackiej uzyskuje się stosując przed posadzeniem roślin nawóz Perlka – cyjanamid wapnia popularnie znanym...
Przygotowanie gleby pod nowe nasadzenia
W miejscu poprzedniej plantacji malin założonej w solowym tunelu, gdzie uprzednio testowano kilkanaście odmian malin w uprawie na podwójny zbiór w ramach projektu Malinowe...
Dlaczego warto stosować nawóz Perlka w uprawie malin (półfinał Malinowe Factory...
Jednym z produktów z powodzeniem stosowanych na plantacjach w Karczmiskach w ramach projektu Malinowe Factory jest nawóz Perlka - cyjanamid wapnia popularnie znanym jako...